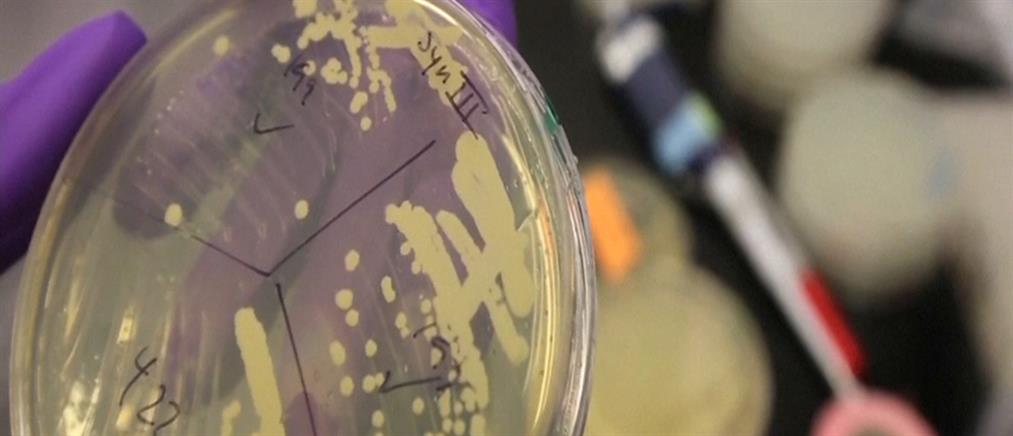

Ειδήσεις23-03-2017 16:14
Ένα βήμα πιο κοντά στη δημιουργία τεχνητής ζωής με “κατά παραγγελία” DNA
Οι επιστήμονες έκαναν ένα μεγάλο βήμα για τη δημιουργία πολύπλοκης συνθετικής ζωής στο εργαστήριο.
antennanews.gr
Οι επιστήμονες έκαναν ένα μεγάλο βήμα για τη δημιουργία πολύπλοκης συνθετικής ζωής στο εργαστήριο.